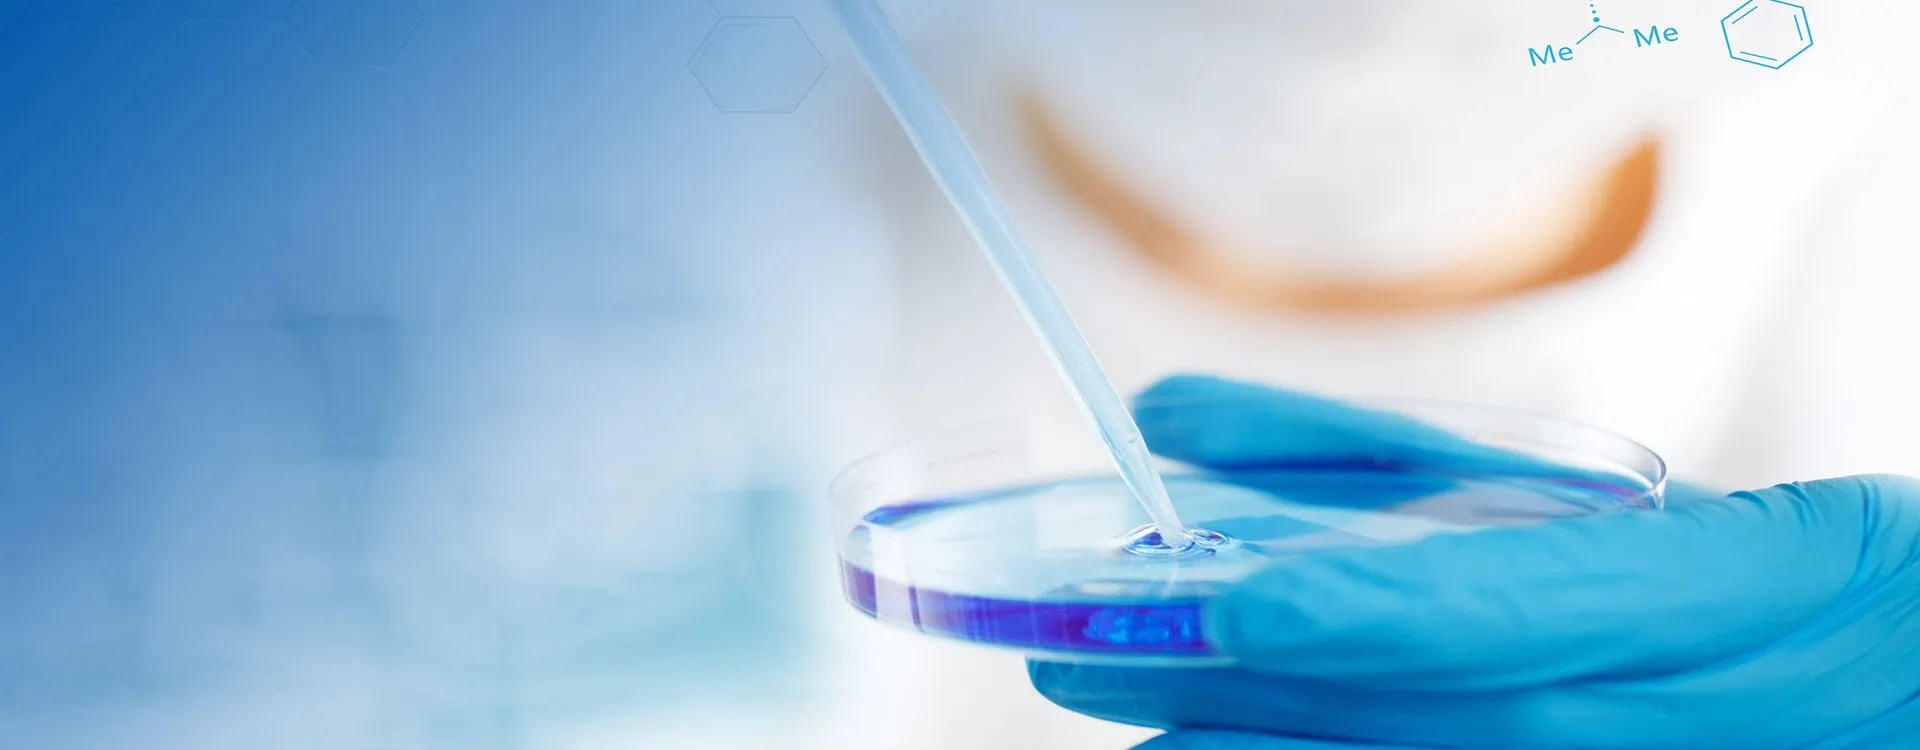

On Chemball
My Chemball
+86-571-8627 3270

TIANJIN ZHENTAI CHEMICAL CO., LTD.
TIANJIN ZHENTAI CHEMICAL CO., LTD.
Main Products:
Sodium Bisulfite / N-Ethylethylenediamine / Sodium Bisulfate / Sodium Metabisulfite
VERIFIEDMANUFACTURINGCOMPANY
Business Type
Manufacturing
Total Employees
0-50
People
Plant Size
15
Acres
Production Experience
21+
Years
Registered Capital
CNY 3 Million
ABOUT US
TIANJIN ZHENTAI CHEMICAL CO., LTD.
TIANJIN ZHENTAI CHEMICAL CO., LTD, is Located at Tianjin zhongwang high-tech development Zone and Covering an area of 10,000M2,is a Chemical high-tech group company with an integrated system of researching and development, production, and marketing and sales ability. Now we mainly produce organic chemicals of N-Ethyl-Ethylenediamine, and inorganic chemicals of Sodium Bisulphate, Sodium metabisulphite, Sodium Sulphite anhydrous, Sodium Bisulphite, Potassium Bisulfate etc.
View More

COMPANY INTRODUCTION
Nearest Port
Tian Jin Port
Nearest Airport
Tianjin binhai international airport
Nearest Key City
Beijing
Distance to Key City
170KM






TELL US WHAT YOU NEED
Submit Requirement
CONTACT US
TIANJIN ZHENTAI CHEMICAL CO., LTD.
-
-
Zhongwang town, Jinghai, Tianjin, China
Send Email